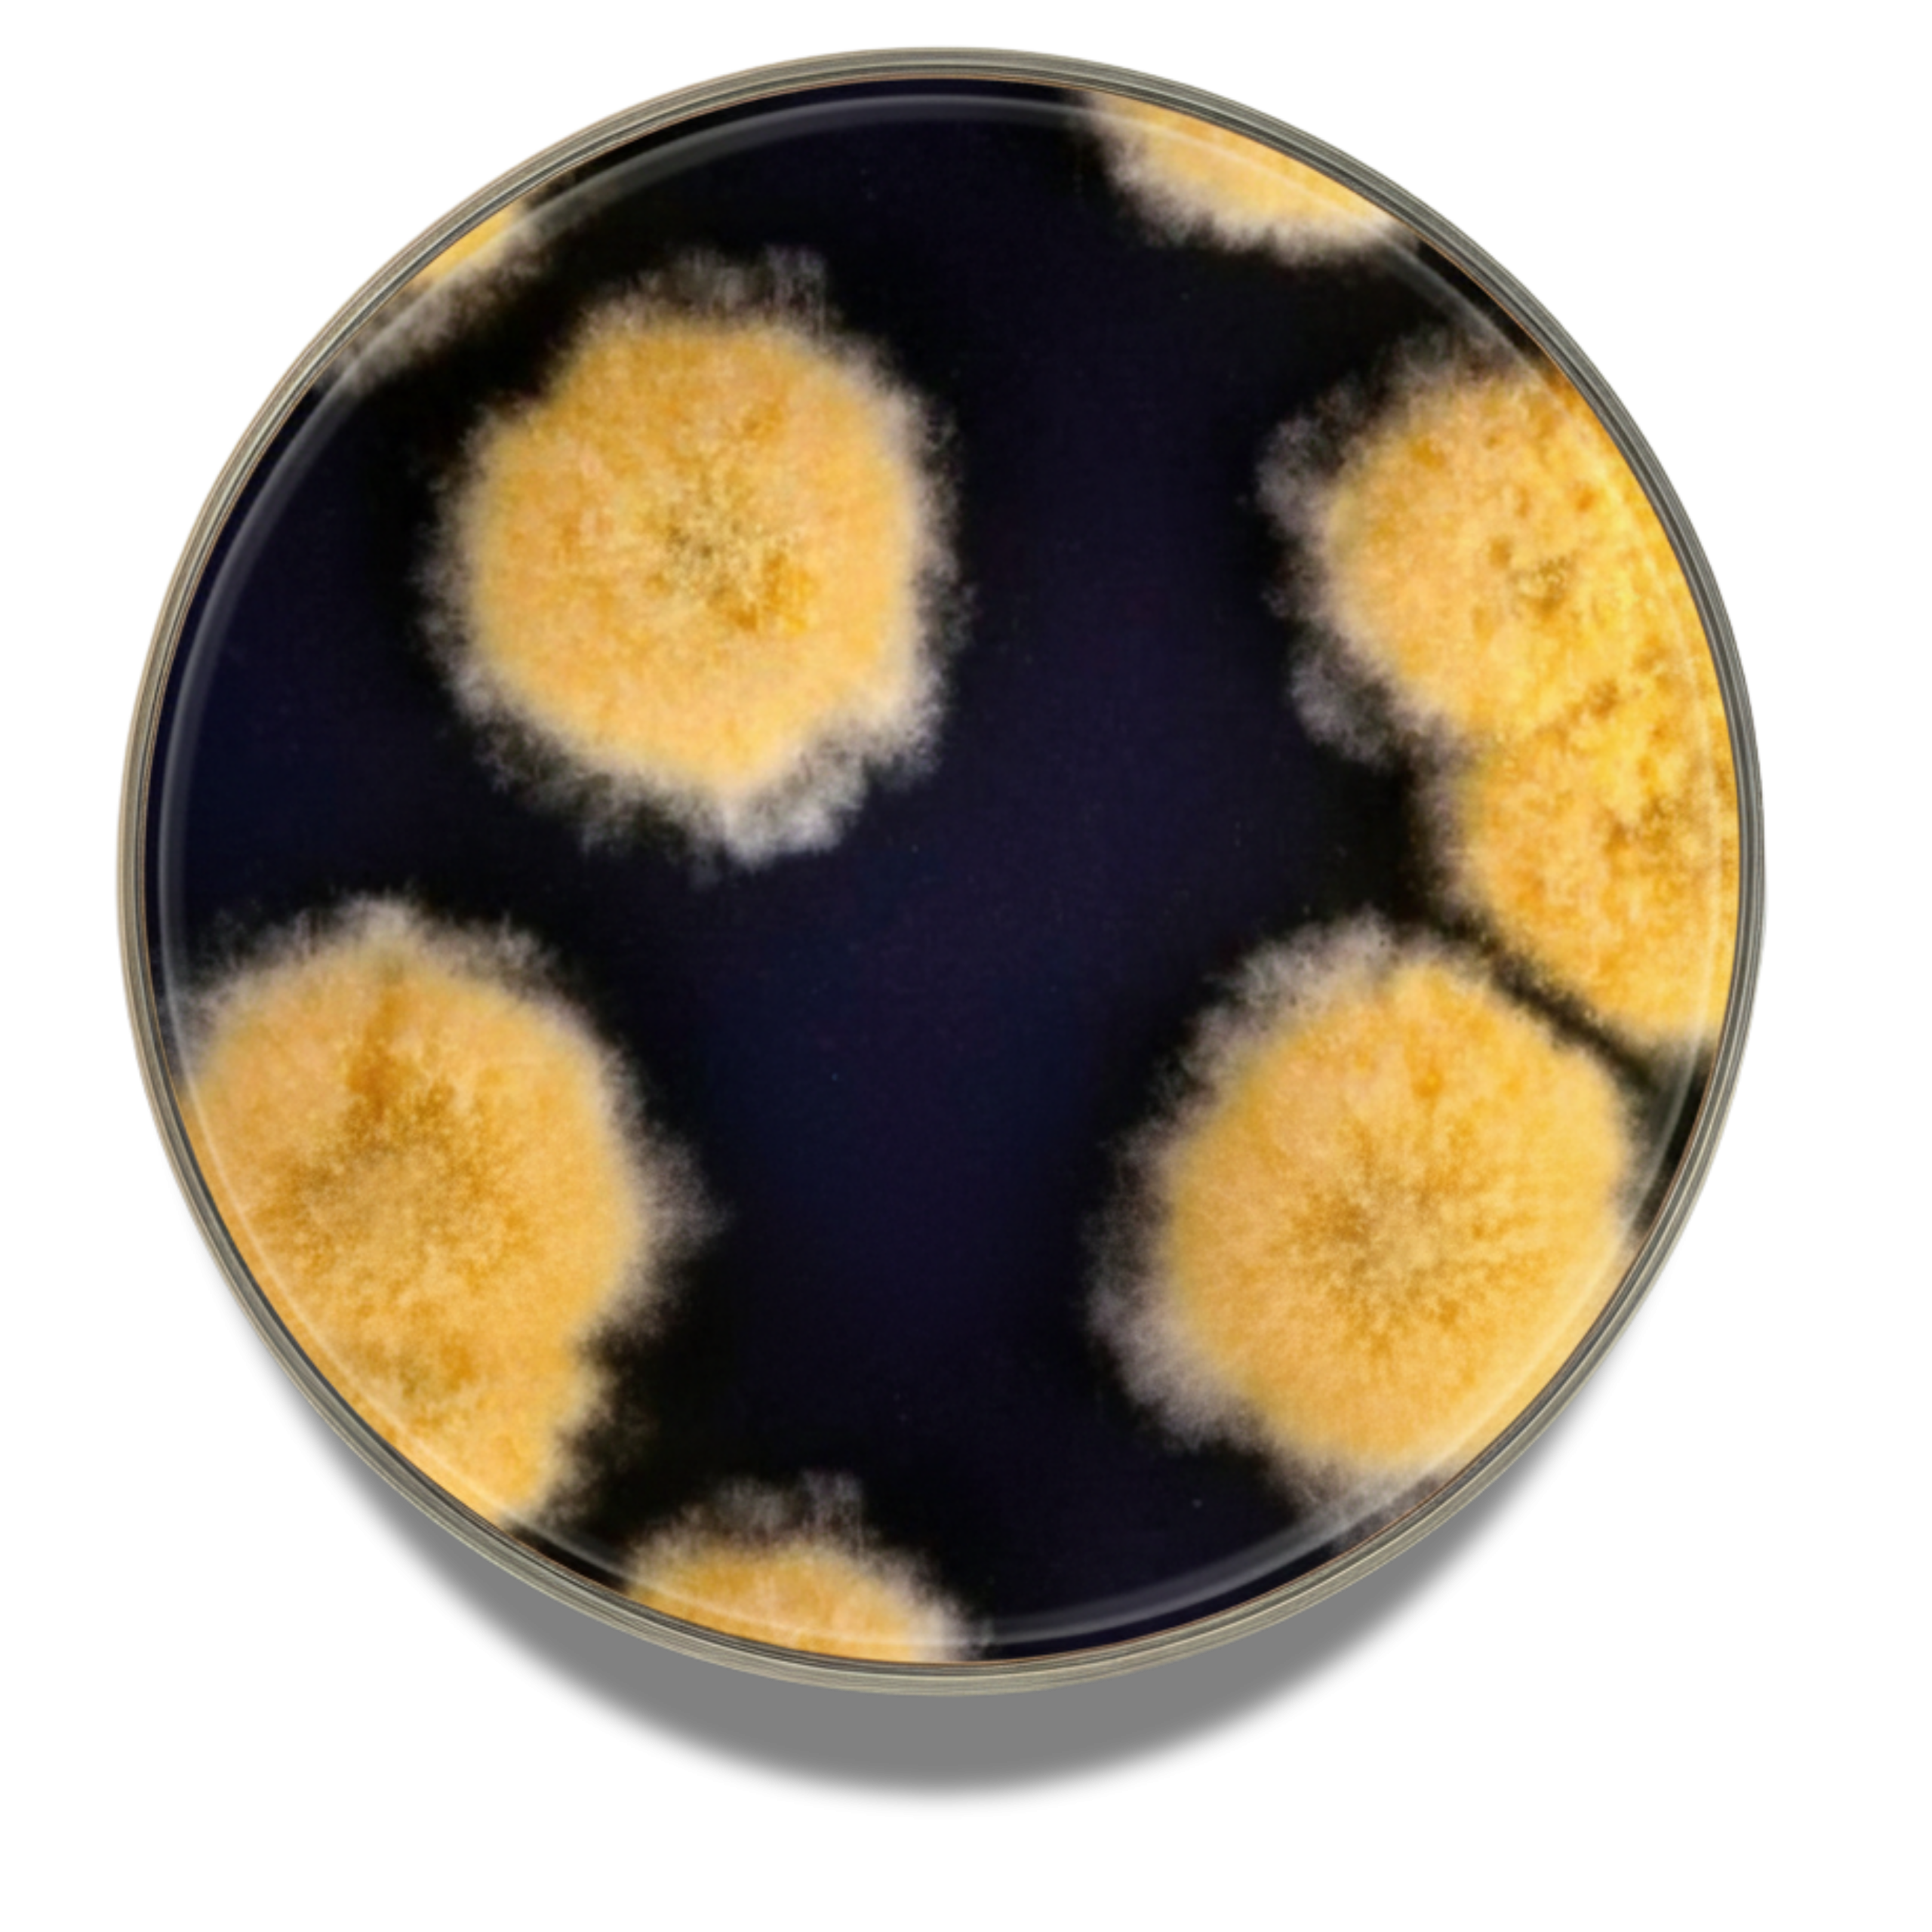

- Wishlist
- SKU : 4013942
- 500 g
Additional Info
| Brand |
BioLife |
|---|
Culture medium completed with chloramphenicol for the enumeration of
yeasts and moulds in foods and animal feeding stuffs with water activity
less than or equal to 0.95 (ISO 21527-2).
Be the first to review “DG 18 AGAR BASE” Cancel reply
You must be logged in to post a review.
Reviews
There are no reviews yet.